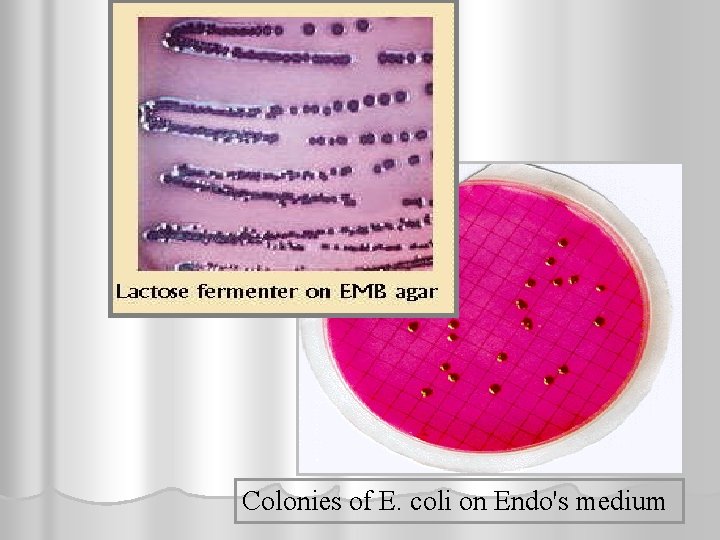
Colonies of E. coli on Endo's medium
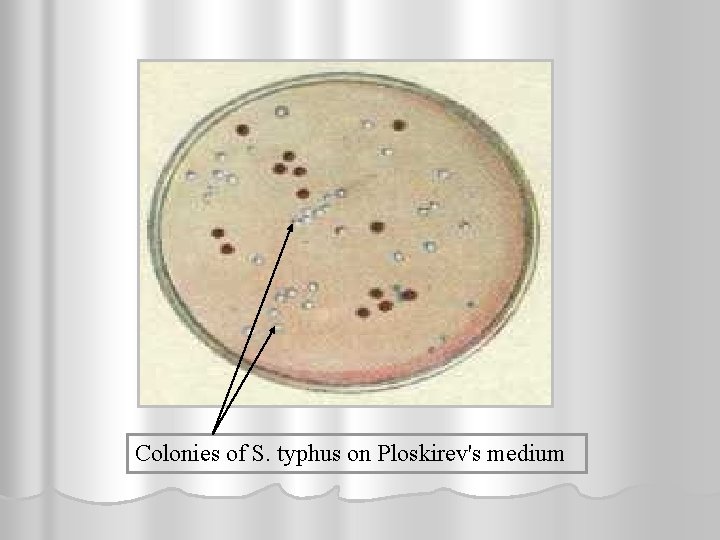
Colonies of S. typhus on Ploskirev's medium
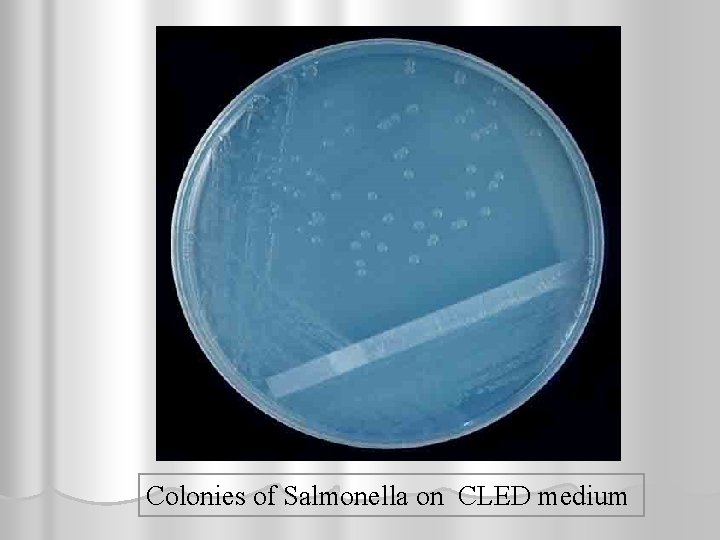
Colonies of Salmonella on CLED medium
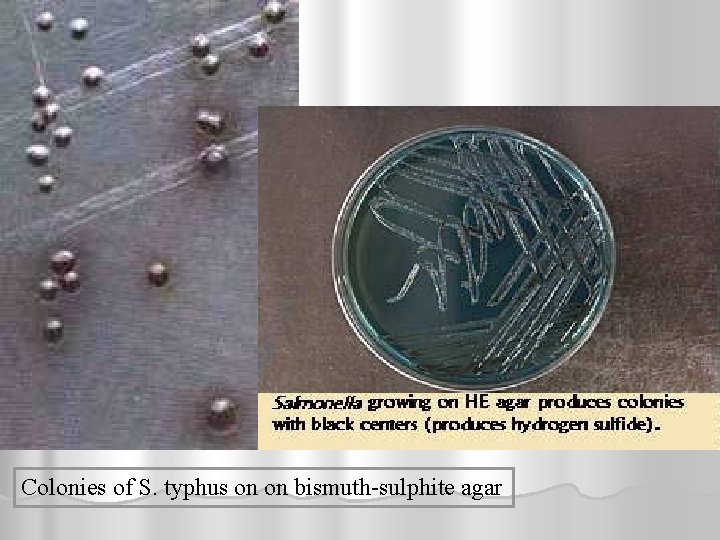
Colonies of S. typhus on on bismuth-sulphite agar

Chair of Medical Biology Microbiology Virology and Immunology

Chair of Medical Biology, Microbiology, Virology, and Immunology PATHOGENIC ENTEROBACTERIACEAE Lecturer As. O. B. Kuchmak

Classification of the Enterobacteriaceae Genera Escherichia Edwardsiella Shigella Salmonella Citrobacter Enterobacter Serratia Providencia Yersinia Klebsiella Hafnia Proteus Morganella Erwinia



The organism was isolated from feces in 1885 by T. Escherich. E. coli is a common inhabitant of the large intestine of humans and mammals. It is also found in the guts of birds, reptiles, amphibians, and insects. The bacteria are excreted in great numbers with the feces and are always present in the external environment (soil, water, foodstuffs, and other objects).

Escherichia coli. Morphology. E coli are straight rods measuring 0. 40. 7 in breadth and 1 -3 in length. There are motile and non-motile types.

Scanning electron micrograph


Cultivation. Colonies of E. coli on meat-peptone agar
Colonies of E. coli on Endo's medium

Colonies of E. coli on Ploskirev's medium

Colonies of E. coli on blood agar

Escherichia coli is highly motile and will show turbidity throughout the tube.

Fermentative properties. “+” -ve test “—” -ve test Positive (left) reactions of isolates E. coli in glucose fermentation broth. Note the formation of acid (yellow color) and gas. Observe the bubble in the Durham tube.

Indole reaction A. Salmonella B. E. coli is the positive microbe. A B

E. coli can reduce nitrate to nitrite. Note the bubble formation. Catalase positive

Toxin production. a gluco-lipo-protein complex with which their toxic, antigenic, and immunogenic properties endotoxins thermolabile neurotropic exotoxins haemotoxins pyrogenic substances, proteinases, deoxyribonucleases, urease, phosphatase hyaluronidase aminoacid decarboxylases

Antigenic structure. The antigenic structure of E. coli is characterized by variability and marked individuality. Along with the H- and O-antigens, the presence of other antigens has been shown in some strains, i. e. the surface somatic (membranous, capsular) K-antigens which contain thermolabile L- and B-antigens and thermostable A- and M-antigens. On the basis of antigenic structure an antigenic formula is derived which fully reflects the antigenic properties of the strain For example, one of the most widely spread serotypes is designated 0111 : K 58 : H 2.

Pathogenesis of E. coli diarrheal disease

Pathogenesis and diseases in man. Definite E. coli serogroups are capable of causing various acute intestinal diseases in humans: Ø the causative agents of colienteritis in children are Ogroups-25, -26, -44, -55, -86, -91, -114, -119, 125, -126, -127, -128, -141, -146, and others (they cause diseases in infants of the first months of life and in older infants); Ø the causative agents of dysentery-like diseases are E. coli of the O-groups-23, -32, -115, -124, -136, -143, 144, -151, and others; Ø the causative agents of cholera-like diarrhoea are the O -groups-6, -15, -78, -148, and others, they produce thermolabile and thermoresistant enterotoxins.



Escherichia coli Diarrhea-producing E. coli Virulence Factors Enteroroxigenic E. coli Heat-labile toxin (LT) Heat-stable toxin (ST) Colonization factors (fimbriae) Enterohernorrhagic E. coli Shiga like toxin (SLT-I) Shiga like toxin II (SLF-II) Colonisation factors (fimbriae) Enteroinvasive E. coli Shiga like toxin (SLT-I) Shiga like toxin II (SLF-II) Ability to invade epithelial cells Enteropathogenic E. coli Adhesin factor for epithelial cells Urinary trace infections P- fimbriae Meningitis K-1 capsule

Enterotoxigenic Escherichia coli. Enterotoxin-producing E coli, called enterotoxigenic E. coli (ETEC), produce one or both of two different toxins – a heat labile toxin called LT and a heatstable toxin called ST.

Enterohemorrhagic Escherichia coli (EHEC) is the etiologic agent of hemorrhagic colitis, a disease characterized by severe abdominal cramps and a copious, bloody diarrhea. These organisms are also known to cause a condition termed hemolyticuremic syndrome (HUS), which is manifested by a hemolytic anemia, thrombocytopenia (decrease in the number of blood platelets), and acute renal failure.

Enteroinvasive Escherichia coli. The disease produced by the enteroinvasive E. coli (EIEC) is indistinguishable from the dysentery produced by members of the genus Shigella, although the shigellae seem to be more virulent because considerably fewer shigellae are required than EIEC to cause diarrhea. The key virulence factor required by the EIEC is the ability to invade the epithelial

Enteropathogenic Escherichia coli (EPEC). The ability of the EPEC to cause diarrhea. EPEC strains routinely have been considered noninvasive, but data have indicated that such strains can invade epithelial cells in culture. However, EPEC strains do not typically cause a bloody diarrhea, and the significance of cell invasion during infection remains uncertain.




Immunity. In individuals who had suffered from diseases caused by pathogenic E. coli serovars, cross immunity is not produced owing to which reinfection may occur.

Laboratory diagnosis. Tested material: the patients' faeces, throat and nasal discharges, material obtained at autopsy (blood, bile, liver, spleen, lungs, contents of the small and large intestine, pus), water, foodstuffs, and samples of washings from objects and hands of staff of maternity hospitals, and dairy kitchens

The tested material is inoculated onto solid nutrient media (Endo's, Levin's) and, simultaneously, onto Ploskirev's media. Blood is first inoculated into broth and then subcultured on solid media when development of a septic process is suspected. The pure culture isolate is identified by its morphological, cultural, biochemical, serological, and biological properties.

The corresponding O-group to which an enteropathogenic-serovars belong is determined by means of the agglutination reaction. Besides, the immunofluorescence method employing type specific labelled sera is also used. It yields a preliminary answer in one to two hours. In serological diagnosis of colienteritis beginning with the third to fifth day of the disease the indirect haemagglutination reaction is used which excels the agglutination reaction in sensitivity.

E. coli by immunofluorescence method

Treatment. Patients with colienteritis are prescribed ü antibiotics (tetracycline with vitamins C, B 1 and B 2) ü biopreparations (coli autovaccine, coli bacteriophage, colicin, bacterin, lactobacterin, bificol, bifidumbacterin). ü Physiological solutions with glucose are injected for controlling toxicosis.

Prophylaxis. To prevent diseases caused by pathogenic serovars of E. coli, special attention is given to early identification of individuals suffering from colienteritis, and also to their hospitalization and effective treatment. Regular examination of personnel is necessary in children's institutions as well as of mothers whose children are suffering from dyspepsia. Considerable importance is assigned to observation of sanitary regulations in children's institutions, infant-feeding centres, maternity hospitals, and children's nurseries. Protection of water and foodstuff's from contamination with faeces, the control of flies, and gradual improvement of standards of hygiene of the population are also particularly important.

Sanitary significance of E. coli. This organism is widely spread in nature. It occurs in soil, water, foodstuff's, and on various objects. For this reason E. coli serves as an indicator of faecal contamination of the external environment. Detection of E. coli is of great importance in estimating the sanitary index of faecal contamination of water, foodstuff's, soil, beverages, objects, and handwashings. The degree of contamination of water, soil and foodstuff's is determined by the coli titre or coli index (these terms have been discussed in the chapter concerning the spread of microbes in nature).

Salmonella Enteric Fever and Paratyphoid Salmonellae: Salmonella typhi Salmonella paratyphi A Salmonella schottmuelleri (S. paratyphi B)

Salmonella Morphology. The morphology of the typhoid and paratyphoid salmonella corresponds with the general characteristics of the Enterobacteriaceae family. Most of the strains are motile and possess flagella, from 8 to 20 in number.

Salmonella typhi Scanning electron micrograph Gram’s staining

Cultivation. Colonies of S. paratyphi on Ploskirev's medium
Colonies of S. typhus on Ploskirev's medium

Colonies of Salmonella on Mac-Conkey medium
Colonies of Salmonella on CLED medium
Colonies of S. typhus on on bismuth-sulphite agar

Fermentative properties.

Toxin production. S. typhi contains gluco-lipo-protein complexes. The endotoxin is obtained by extracting the bacterial emulsion with trichloracetic acid. This endotoxin is thermostable, surviving a temperature of 120° C for 30 minutes, and is characterized by a highly specific precipitin reaction and pronounced toxic and antigenic properties. Investigations have shown the presence of exotoxic substances in S. typhi which are inactivated by light, air, and heat (80° C), as well as enterotropic toxin phosphatase, and pyrogenic substances.

Antigenic structure. S. typhi possesses a flagella H-antigen and thermostable somatic O- and Vi-antigens. All three antigens give rise to the production of specific antibodies in the body, i. e. H-, O-, and Viagglutinins. H-agglutinins bring about a largeflocculent agglutination, while 0 - and Vi-agglutinins produce fine-granular agglutination.


Classification. The salmonellae of typhoid fever and paratyphoids together with the causative agents of toxinfections have been included in the genus Salmonella (named after the bacteriologist D. Salmon) on the basis of their antigenic structure and other properties. At present, about 2000 species and types of this genus are known. F. Kauffmann and P. White classified the typhoidparatyphoid salmonellae into a number of groups according to antigenic structure and determined 65 somatic O-antigens. For instance, S. typhi (group D) contains three different O-antigens — 9, 12, and Vi. S. paratyphi A alone constitutes group A, and S. schottmuelleri belongs to group B.

Pathogenesis and diseases in man. The causative agent is primarily located in the intestinal tract. Infection takes place through the mouth (digestive stage). Cyclic recurrences and development of certain pathophysiological changes characterize the pathogenesis of typhoid fever and paratyphoids. There is a certain time interval after the salmonellae penetrate into the intestine, during which inflammatory processes develop in the isolated follicles and Peyer's patches of the lower region of the small intestine (invasive stage).

As a result of deterioration of the defence mechanism of the lymphatic apparatus in the small intestine the organisms enter the blood (bacteriemia stage). Here they are partially destroyed by the bactericidal substances contained in the blood, with endotoxin formation. During bacteraemia typhoid salmonellae invade the patient's body, penetrating into the lymph nodes, spleen, bone marrow, liver, and other organs (parenchymal diffusion stage). This period coincides with the early symptoms of the disease and lasts for a week.

During the second week of the disease endotoxins accumulate in Peyer's patches, are absorbed by the blood, and cause intoxication. The general clinical picture of the disease is characterized by status typhosus, disturbances of thermoregulation, activity of the central and vegetative nervous systems, cardiovascular activity, etc.

On the third week of the disease a large number of typhoid bacteria enter the intestine from the bile ducts and Lieberkuhn's glands. Some of these bacteria are excreted in the faeces, while others reenter the Peyer's patches and solitary follicles, which had been previously sensitized by the salmonellae in the initial stage. This results in the development of hyperergia and ulcerative processes. Lesions are most pronounced in Peyer's patches and solitary follicles and may be followed by perforation of the intestine and peritonitis (excretory and allergic stage).

The typhoid-paratyphoid salmonellae together with products of their metabolism induce antibody production and promote phagocytosis. These processes reach their peak on the fifth-sixth week of the disease and eventually lead to recovery from the disease. Clinical recovery (recovery stage) does not coincide with the elimination of the pathogenic bacteria from the body. The majority of convalescents become carriers during the first weeks following recovery, and 3 -5 per cent of the cases continue to excrete the organisms for many months and years after the attack and, sometimes, for life.

Inflammatory processes in the gall bladder (cholecystitis) and liver are the main causes of a carrier state since these organs serve as favourable media for the bacteria, where the latter multiply and live for long periods. Besides this, typhoid-paratyphoid salmonellae may affect the kidneys and urinary bladder, giving rise to pyelitis and cystitis. In such lesions the organisms are excreted in the urine.

Immunity acquired after typhoid fever and paratyphoids is relatively stable but relapses and reinfections sometimes occur. Antibiotics, used as therapeutic agents, inhibit the immunogenic activity of the pathogens, which change rapidly and lose their O- and Viantigens.

Laboratory diagnosis. The present laboratory diagnosis of typhoid fever and paratyphoids is based on the pathogenesis of these diseases. 1. Isolation of haemoculture. Bacteraemia appears during the first days of the infection. Thus, for culture isolation 10 -15 ml of blood (15 -20 ml during the second week of the disease and 30 -40 ml during the third week) are inoculated into 100, 150 and 200 ml of 10 per cent bile broth, after which cultures are incubated at 37° C and on the second day subcultured onto one of the differential media (Ploskirev's, Endo's, Levin’s) or common meatpeptone agar.

The isolated culture is identified by inoculation into a series of differential media and by the agglutination reaction. The latter is performed by the glass-slide method using monoreceptor sera or by the test-tube method using purified specific sera.

2. Serological method. Sufficient number of agglutinins accumulate in the blood on the second week of the disease, and they are detected by the Widal reaction. Diagnostic typhoid and paratyphoid A and B suspensions are employed in this reaction. The fact that individuals treated with antibiotics may yield a low titre reaction must be taken into consideration. The reaction is valued positive in patient's serum in dilution 1 : 200 and higher. The Widal reaction may be positive not only in patients but also in those who had suffered the disease in the past and in vaccinated individuals. For this reason diagnostic suspensions of O- and H-antigens are employed in this reaction. The sera of vaccinated people and convalescents contain H-agglutinins for a long time, while the sera of patients contain O-agglutinins at the height of the disease.

In typhoid fever and paratyphoids the agglutination reaction may sometimes be of a group character since the patient's serum contains agglutinins not only to specific but also to group antigens which occur in other bacteria. In such cases the patient's blood must be sampled again in 5 -6 days and the Widal reaction repeated. Increase of the agglutinin titre makes laboratory diagnosis easier. In cases when the serum titre shows an equal rise with several antigens, 0 -, H-, and Vi-agglutinins are detected separately.

3. A pure culture is isolated from faeces and urine during the first, second, and third weeks of the disease. The test material is inoculated into bile broth, Muller's medium, Ploskirev's medium, or bismuth sulphite agar. Isolation and identification of the pure culture are performed in the same way as in blood examination. Selective media are recommended for isolation of the typhoid-paratyphoid organisms from water, sewage, milk, and faeces of healthy individuals. These media slightly inhibit the growth of pathogenic strains of typhoid-paratyphoid organisms and greatly suppress the-growth of saprophytic microflora.

A reaction for the detection of a rise in the phage titre is employed in typhoid fever and paratyphoid diagnosis. This reaction is based on the fact that the specific (indicator) phage multiplies only when it is in contact with homologous salmonellae. An increase in the number of phage corpuscles in the test tube as compared to the control tube is indicative of the presence of organisms homologous to the phage used. This reaction is highly sensitive and specific and permits to reveal the presence of the salmonellae in various substrates in 11 -22 hours without the necessity of isolating the organisms in a pure culture. The reaction is valued positive if the increase in the number of corpuscles in the tube containing the test specimen is not less than 5 -10 times that in the control tube.

Treatment. üchloramphenicol, oxytetracycline, nitrofuran preparations and ügeneral non-specific treatment (dietetic and symptomatic)

Prophylaxis. Ø timely diagnosis Ø hospitalization of patients, disinfection of the sources, and identification Ø treatment of carriers Ø disinfection of water, safeguarding water supplies from pollution, systematic and thorough cleaning of inhabited areas, fly control, and protection of foodstuff's and water from flies Ø Washing of hands before meals and after using the toilet is necessary Ø regular examination of personnel in food-processing factories for identification of carriers is also extremely important. Ø several varieties of vaccines are prepared: typhoid vaccine (monovaccine), typhoid and paratyphoid B vaccine (divaccine).
- Slides: 66